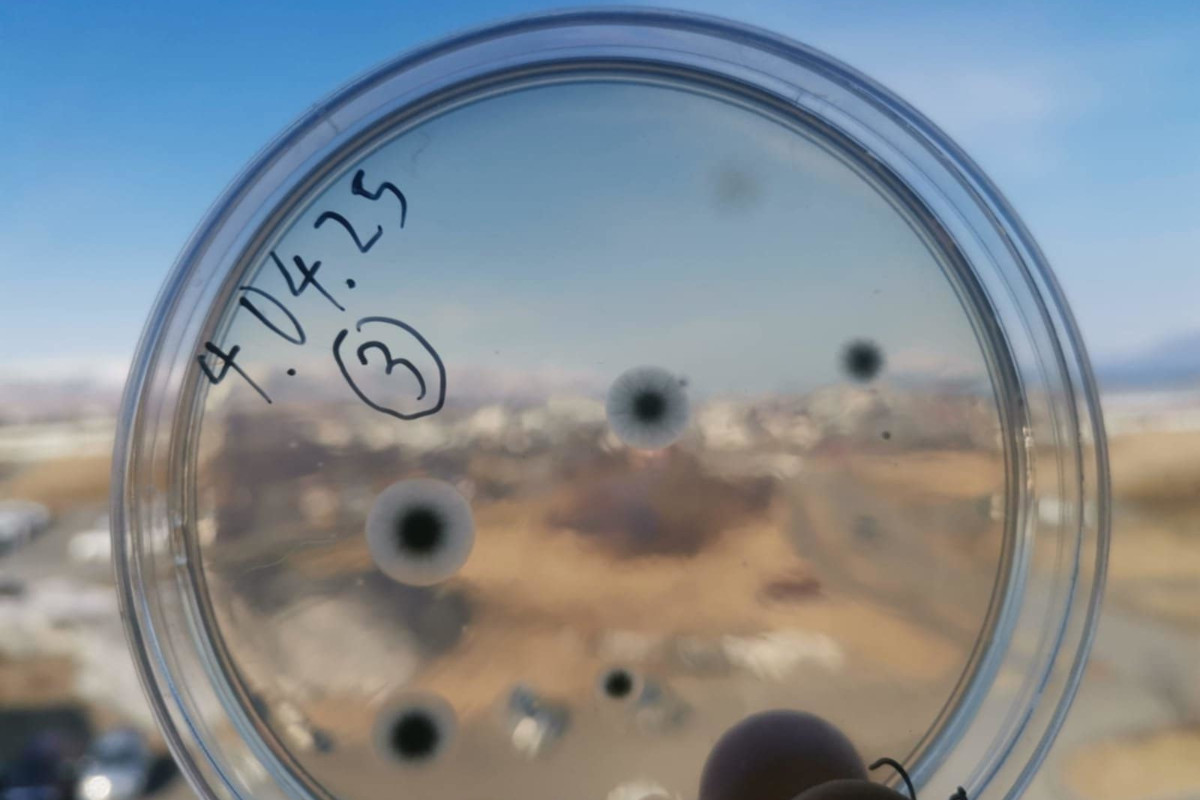
Sveppagró vaxa á ætisskál
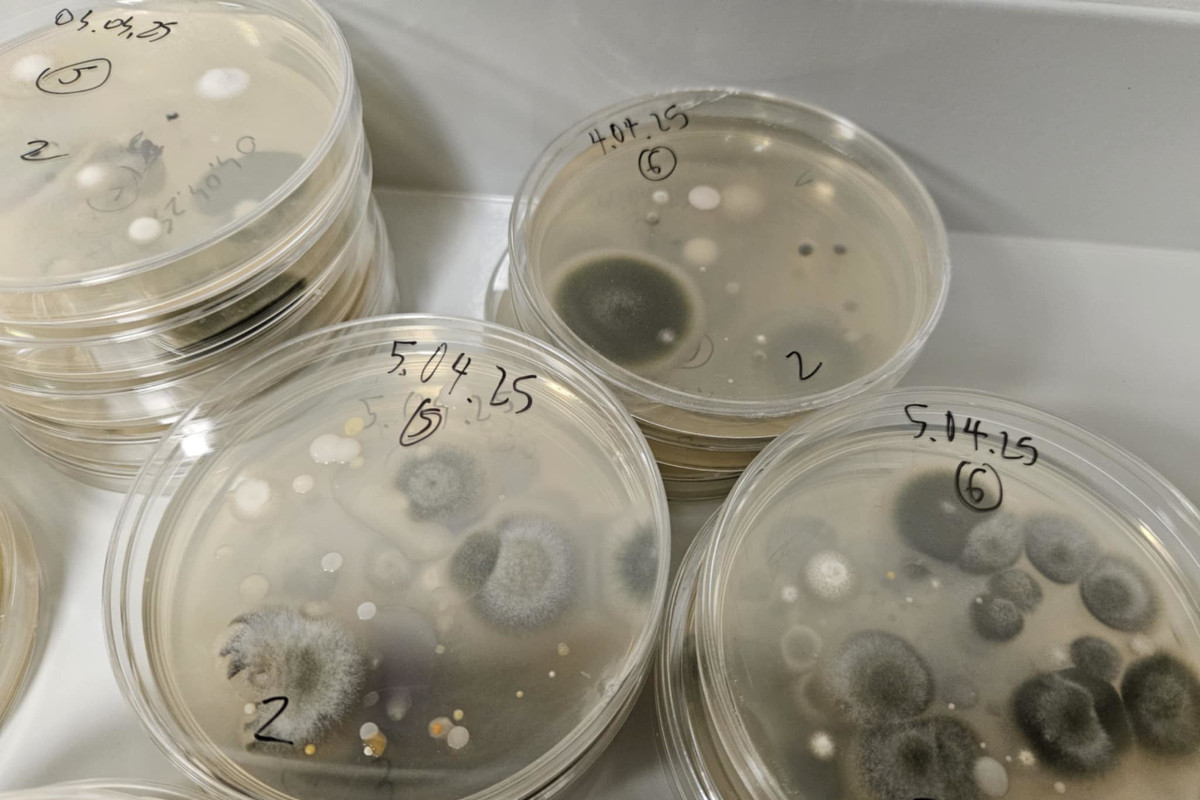
Á ætisskálum vaxa gró sveppa sem fönguð eru úr andrúmslofti.

Ný rannsókn á sveppagróum í andrúmslofti hafin
Náttúrufræðistofnun hefur umsjón með nýju rannsóknarverkefni sem hófst í byrjun apríl og snýr að sveppagróum í andrúmslofti á Íslandi. Markmiðið er að greina útbreiðslu, fjölbreytileika og tímasetningar sveppagróa.
Verkefnið byggir á greiningu langtímagagna úr frjókornavöktun og miðar að því að bæta þekkingu á loftbornum sveppagróum sem geta haft áhrif á öndunarfæri manna. Tegundir á borð við Cladosporium og Alternaria geta haft veruleg áhrif á heilsu manna. Gró þeirra eru algengir loftbornir ofnæmisvaldar sem geta komist djúpt niður í öndunarfæri þar sem þau geta valdið astmaeinkennum og öðrum öndunarfæraeinkennum. Vöktun á útbreiðslu þeirra er því mikilvæg í lýðheilsuskyni, sérstaklega í ljósi þess að loftslagsbreytingar geta haft áhrif á magn og dreifingu þeirra.
Verkefnið er unnið í samstarfi við prófessor Wojciech Pusz frá Landbúnaðar- og lífvísindaháskólanum í Wrocław í Póllandi, en hann vinnur að rannsóknum á loftbornum sveppum á heimskautasvæðum. Með honum er meistaraneminn Maciej Lipiński, sem mun dvelja lengur hér á landi við greiningarvinnu.